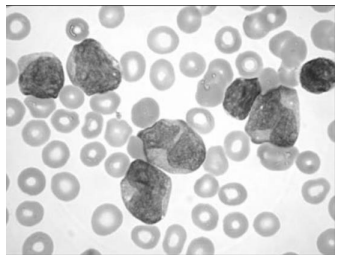
Enunciado 3564063-1

Uma paciente do sexo feminino, 29 anos de idade, procura um
serviço de emergência, com queixas de febre, intensa astenia,
hematúria, epistaxe e manchas roxas no corpo. Esses sintomas
começaram uma semana antes, e vieram piorando rapidamente.
Na emergência, seu hemograma mostrava anemia (hemoglobina
de 6g/dL), trombocitopenia (21.000 plaquetas/µL) e intensa
leucocitose (15.000 leucócitos/ µL).
Foi feito um esfregaço do sangue periférico, que pode ser visto a seguir.

Assinale a opção que apresenta o diagnóstico mais provável para essa paciente
Foi feito um esfregaço do sangue periférico, que pode ser visto a seguir.
Assinale a opção que apresenta o diagnóstico mais provável para essa paciente